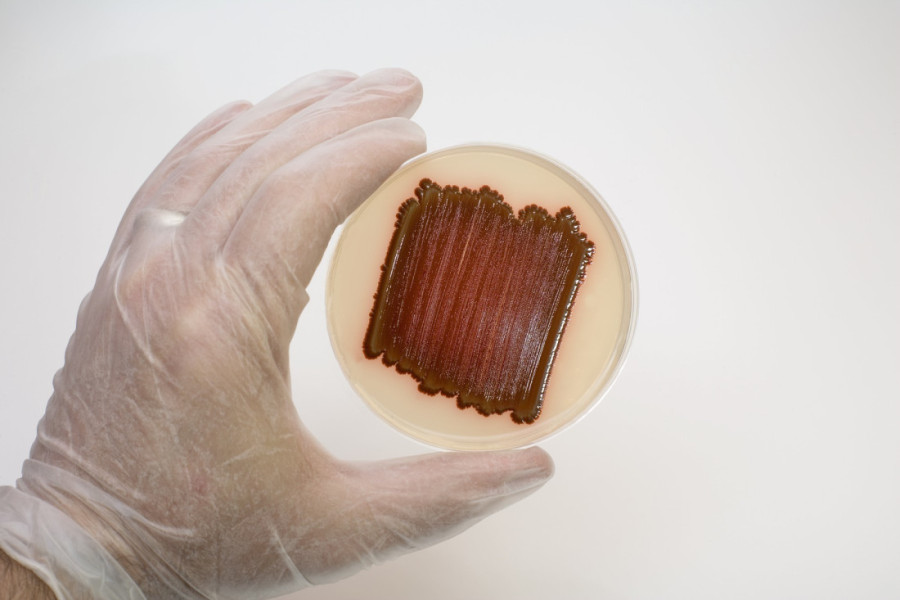

Da li i u vašem kupatilu živi opasna bakterija koja izaziva ozbiljne crevne infekcije?
Liči na plesan, a zapravo je bakterija i još je opasnija

Mnogi su verovatno primetili svetlo narandžastu ili roze plesan koja se pojavljuje u uglovima kupatila. Doktor Karan Rajan objasnio je na TikToku svojim pratiocima da to zapravo nije plesan, već bakterija koja „povraća roze sluz“.
Istakao je da njen rast može biti znak da u vašem domu postoje i druge opasne vrste plesni koje se nalaze u idealnim uslovima za rast.
Doktor Rajan, britanski hirurg, univerzitetski predavač i autor, rekao je da bakterija koja izaziva ovaj problem, poznata kao 'serratia marcescens', može prouzrokovati infekcije u crevima, mokraćnim putevima ili plućima, naročito kod osoba sa oslabljenim imunitetom. Za većinu ljudi, kontakt sa ovom bakterijom obično nije opasan, ali bi trebalo izbegavati da dođe u kontakt sa očima ili otvorenim ranama.
"Za one koji su primetili ovu roze sluz u kupatilu, to nije plesan - to je bakterija - rekao je dr Rajan, objašnjavajući da serratia marcescens 'povraća' roze sluz po vašem kupatilu.
"Ako u vašem domu ima dovoljno vlage da se redovno pojavljuje roze sluz, mogli biste zapravo uzgajati i druge vrste plesni koje mogu izazvati respiratorne probleme ili alergije", rekao je doktor.
Profimedia
Profimedia
Preporuke stručnjaka za prevenciju
Stručnjaci savetuju kako sprečiti rast ove bakterije i drugih opasnih plesni. Prvi korak je sprečiti da bakterija uopšte nastane.
"Prvo pravilo je sprečiti da bakterija raste u početku. Onemogućavanjem njenog rasta, sprečićete i rast drugih opasnih plesni", naglasio je.
Kako biste sprečili rast bakterije, potrebno je održavati kupatilo suvim i dobro provetrenim. Uključite ventilator ili otvorite prozor nakon tuširanja da biste smanjili vlagu. Takođe, redovno čišćenje i dezinfekcija kupatila su ključni, jer, kako kaže doktor Rajan, „vaše kupatilo je prljavije nego što mislite“.
 Profimedia
Profimedia
Doktor Rajan je objasnio kako bakterija raste, naglašavajući da ona voli vlažna mesta i uživa u hranjenju mastima koje se nalaze u sapunima i šamponima, zbog čega je često možete naći u zamagljenom kupatilu.
Za one koji imaju sličan problem, preporučuje se korišćenje sprejeva za čišćenje i dezinfekciju, naročito na rubovima lavaboa i tuš kabina, gde bakterije najčešće nastaju, piše 24sata.
BONUS VIDEO:
Instalirajte našu iOS ili android aplikaciju – 24sedam Vest koja vredi












































Komentari